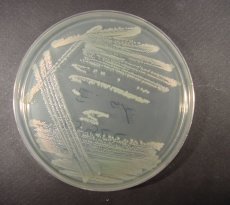
Yeasts and molds

Dealer wanted
Comprehensive Selection of Supplements for Dehydrated Culture Media - New! Specialized Supplements for Optimal Microbiological Media Performance Now available for use with our MicroMedia-branded dehydrated media or as standalone additives – delivering enhanced selectivity, enrichment, and reliability for your lab.
|
Full automatic can lid feeder at Coca-Cola factory - New Unit-Fine Fully Automatic Can Lid Feeder Installed at Coca-Cola Plant |
B20 can lid feeder at Bakalar Brewery -
Unit-Fine Installs First B20 Can Lid Feeder with Round Magazine Loader at Bakalář Brewery
Products
Industrial and environmental microbiology
Industrial microbiology is a special distinct territory regulated by strict local and international standards.For pharmaceutical and cosmetical technology, only limited number of media are authorized to use. In water testing and food testing ,microorganisms potentially pathogenic to humans,to domestical or wild animals or to cultivated plants in agriculture are the targets organisms.
Newsletter
In this newsletter publication we highlight our activities, featuring briefly past and upcoming events, new publications, as well as major news!
MicroMedia Trading House
Address: 10130 Tallin Kiriku Tn 6, Hungary
Phone: +36306013634, Fax: ,
Support: support@micromediatradinghouse.com
Address: 10130 Tallin Kiriku Tn 6, Hungary
Phone: +36306013634, Fax: ,
Support: support@micromediatradinghouse.com